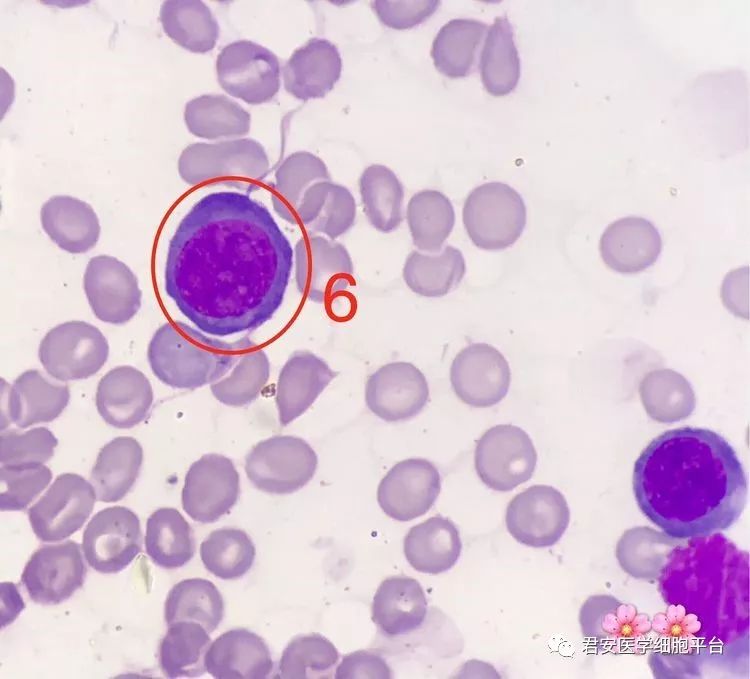
看图识细胞(第61期)_核仁
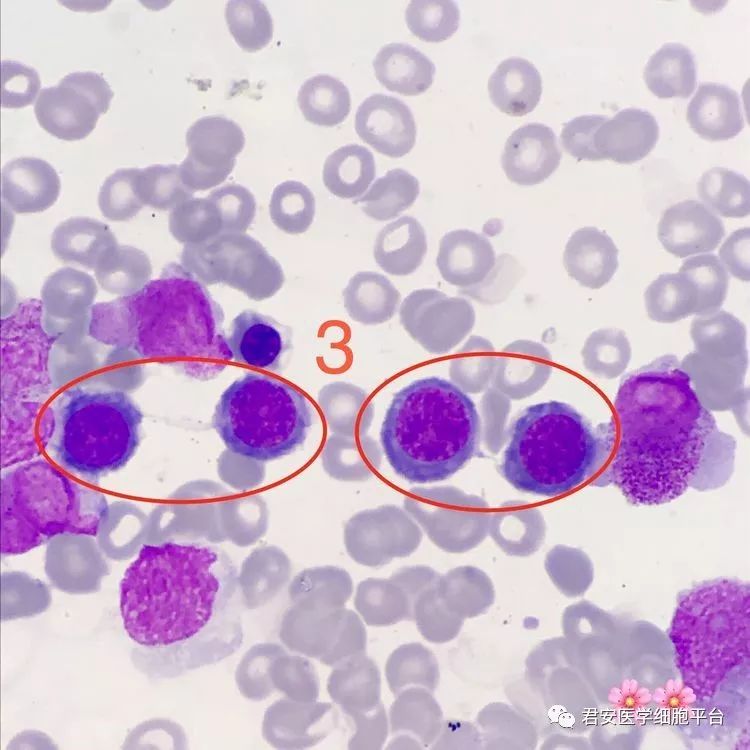
看图识细胞(第61期)_核仁

细胞核仁

核仁在哪里?是深紫色的是细胞核,是比细胞核更深的,在它里面的哪些吗?
图片尺寸650x983
该类异常细胞体积大,核大,部分核仁明显,胞膜外伪足明显.
图片尺寸1599x1199
核仁(nucleolus)通常表现为单一或多个匀质的球形小体,是真核细胞间期
图片尺寸396x424
看图识细胞(第61期)_核仁
图片尺寸750x750
看图识细胞(第61期)_核仁
图片尺寸750x750
细胞核细胞核, 核仁,人体细胞.核的真核 c照片
图片尺寸533x300
看图识细胞(第61期)_核仁
图片尺寸750x679
课件(苏教版七年级上)ppt 植物细胞的主要结构 (核仁) (核膜) 细胞
图片尺寸1080x810
细胞核, 核仁, 人体细胞
图片尺寸700x700
看图识细胞(第61期)_核仁
图片尺寸750x750
看图识细胞(第61期)_核仁
图片尺寸750x750
cell) lm:细胞轮廓不清,核呈三角形或 不规则性,染色浅,核仁明显
图片尺寸1080x810
请问那些核仁明显的细胞是癌细胞吗?图3呢?谢谢!
图片尺寸965x724
充满膜内均匀透明的胶状物质核仁:折光强的球状小体核膜:细胞核外的一
图片尺寸406x477
一 细胞核的功能 细胞核的结构 染色质 核仁 内膜 外膜 核孔
图片尺寸1080x810
核质 (英语:nucleoplasm)是真核细胞中细胞核内除核仁外,所含的
图片尺寸300x245
细胞核是核中除染色质与核仁以外的成分,包括核液与核骨架两部分.
图片尺寸300x274
19 写美篇答案:成骨细胞 解析:该类细胞直径约20-40um,常为长椭圆形或
图片尺寸1269x952
知识回顾:细胞核结构及功能 染 色 质 核膜 核仁 核孔
图片尺寸1080x810
支持细胞可以通过它们的大核仁图片素材
图片尺寸375x300

.svg/300px-Diagram_human_cell_nucleus_(zh-cn).svg.png)



